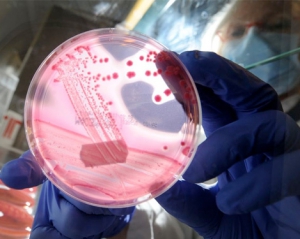

В Германии власти земли Нижняя Саксония заявили, что причиной вспышки заражения кишечной палочкой E.coli, охватившей Европу, скорее всего, стали побеги бобовых, выращенные в местных теплицах. В частности, речь идет о пророщенных фасоли, сое, чечевице и горохе.
Немецкие средства массовой информации сообщают также, что власти призвали население не употреблять в пищу не только ростки бобовых, но и побеги брокколи, чеснока, редиса и редьки, которые используются для приготовления салатов. Однако полной уверенности у экспертов нет до сих пор: окончательные результаты анализов ожидаются в понедельник.
Ферма, где был обнаружен предположительный источник заражения, в настоящее время закрыта. Местные власти не исключают, что кишечная палочка может быть вскоре обнаружена и в других немецких хозяйствах.
В то же время некоторые немецкие ветеринары и врачи-лаборанты выдвигают свою версию: они предполагают, что источник опасной кишечной палочки находится в биогазовых установках.
По мнению Бернда Шоттдорфа, основателя крупнейшей частной медицинской лаборатории в Европе Schottdorf MVZ, в бродильных аппаратах этих установок образуются бактерии, которых не существовало прежде. "Они перекрещиваются и сплавляются друг с другом, но что там точно происходит, пока толком не исследовано", - сказал Шоттдорф в интервью. Поэтому следует безотлагательно исследовать биогазовые установки на предмет наличия в них возбудителей болезни, считает Шоттдорф.
Другие ученые подтверждают, что нынешней весной очень долго не было дождей, с растений не были смыты остатки зараженный бактериями биоотходов, используемого как удобрение. А отраслевое объединение Biogas, между тем, обратило внимание на то, что нормы гигиены Евросоюза предписывают гигиеническую обработку биогазовых установок. По данным объединения, возможные бактерии убиваются в результате тепловой обработки бродильного субстрата - в течение часа он прогревается при температуре 70 градусов.
На данный момент от инфекции умерли 22 человека и заболели около 2 тысяч человек, многие находятся в тяжелом состоянии. Все инфицированные проживают в Германии или же побывали там не так давно. В Германии зарегистрировано наибольшее количество случаев заболевания - более 1500, у 627 пациентов диагностирован гемолитико-уремический синдром, многие из них находятся в тяжелом состоянии.
Комментарии
2